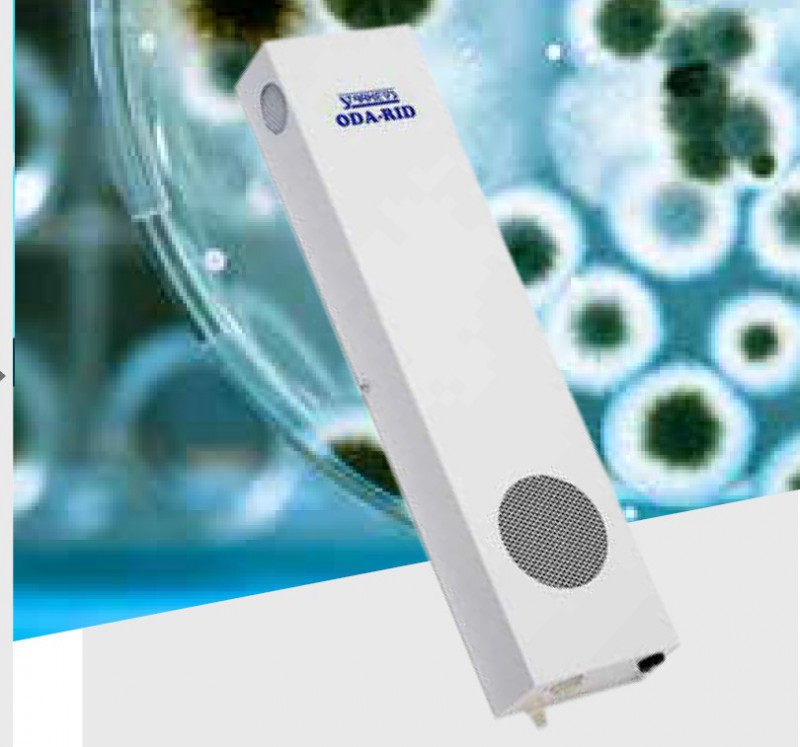

Barnd:ODA-RID
Ship:3天内
Send inquiry
- DIMENSIONS
H: 31cm W: 19cm D: 7cm
- WEIGHT
2kg
- COVERAGE
Wall mounted: 240m2 - Ceiling-suspended: 480m2
- FINISH
White
- TUBE DATA
• 1 x G8T5VH Ozone
- DIMENSIONS
H: 31cm W: 19cm D: 7cm
- WEIGHT
2kg
- COVERAGE
Wall mounted: 240m2 - Ceiling-suspended: 480m2
- FINISH
White
- TUBE DATA
• 1 x G8T5VH Ozone